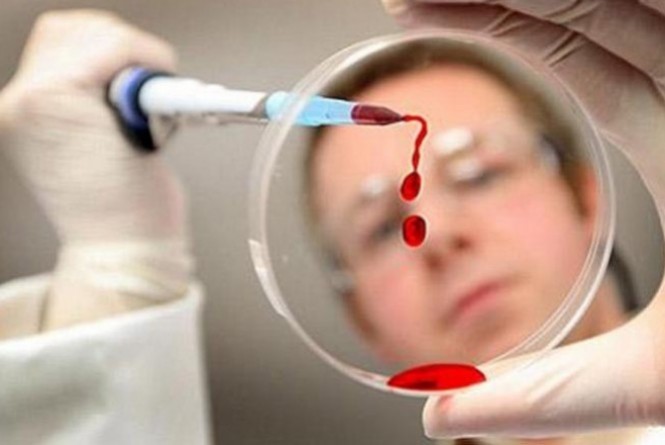

Joaçaba registra em 1 ano 26 novos casos de AIDS
Joaçaba fechou o ano de 2016 com 26 novos casos de AIDS. A informação foi repassada a Rádio Catarinense pelo Departamento de Doenças Sexualmente Transmissíveis da Secretaria Municipal de Saúde. No total mais de 250 pessoas estão em tratamento e acompanhamento em razão do HIV. Estima-se que o número deve ser maior, já que muitos portadores não sabem que são detentores da doença. As unidades de saúde de Joaçaba oferecem o chamado teste rápido. Em menos de 40 minutos o paciente descobre se tem o vírus ou não. Outro dado que preocupa é o aumento de casos entre jovens, que mesmo com informações, se arriscam mais nas relações sem uso de preservativos.
Por Marcelo Santos







